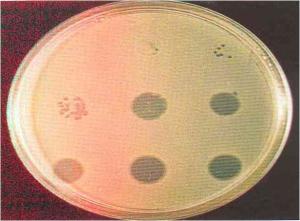
噬菌斑

噬菌斑

噬菌体裂解病原青枯菌形成的噬菌斑
图片尺寸800x600
噬菌斑
图片尺寸268x180
噬菌斑的介绍
图片尺寸338x600
求助为什么同一个噬菌体有的噬菌斑长得大小不一
图片尺寸3000x4000![图中出现不同大小的噬菌斑,这可能是(). [图]a,不同噬.](https://i.ecywang.com/upload/1/img0.baidu.com/it/u=1684788725,3204356760&fm=253&fmt=auto&app=138&f=JPEG?w=405&h=416)
图中出现不同大小的噬菌斑,这可能是(). [图]a,不同噬.
图片尺寸405x416
菌落中间有很多的斑点一噬菌斑.
图片尺寸1912x1811
接种噬菌体后在细菌培养物上出现的噬菌斑.
图片尺寸607x403
噬菌斑
图片尺寸300x221
蛭弧菌在双层平板上产生的噬菌斑
图片尺寸211x220
噬菌斑
图片尺寸800x600
噬菌斑的培养和观察方法
图片尺寸853x873
一种基于病毒噬斑图像的自动噬斑测定方法技术
图片尺寸1000x710
这个是噬菌斑吗?新手做噬菌体滴度,求帮忙
图片尺寸4160x3120
无良商家用芽孢杆菌冒充蛭弧菌,价格相差巨大!转起,踢爆骗局
图片尺寸640x587
蓝色噬菌体斑
图片尺寸1440x810
图:噬菌斑其次,根据噬菌体的来源和侵染特性等选择了4株噬菌体为材料
图片尺寸600x800
新型乳酸球菌噬菌体lac62gap621及其用于抑制乳酸球菌增殖的用途
图片尺寸993x1000
乾界生物关于蛭弧菌及其在水产养殖中的使用
图片尺寸1000x487
图 1m1的噬菌斑形态figure 1plaques of phagem1注:a:噬菌体m1感染mr
图片尺寸1653x795
图4浓缩后的金黄色葡萄球菌噬菌斑图5投射电子显微镜下噬菌体结构形态
图片尺寸220x197




![图中出现不同大小的噬菌斑,这可能是(). [图]a,不同噬.](https://i.ecywang.com/upload/1/img0.baidu.com/it/u=1684788725,3204356760&fm=253&fmt=auto&app=138&f=JPEG?w=405&h=416)



















![图中出现不同大小的噬菌斑,这可能是(). [图]a,不同噬.](https://static.jiandati.com/e6e7c96-chaoxing2016-134761.jpeg)